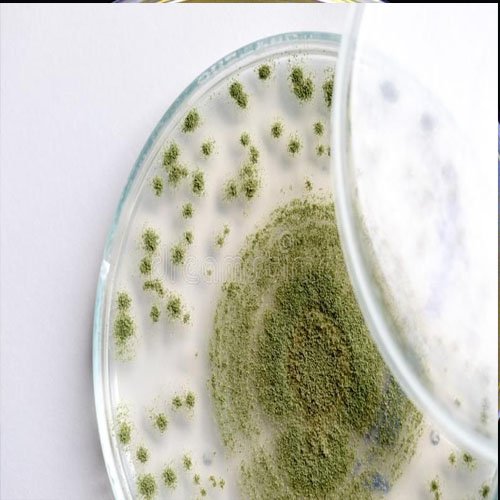
Aspergillus fumigatus
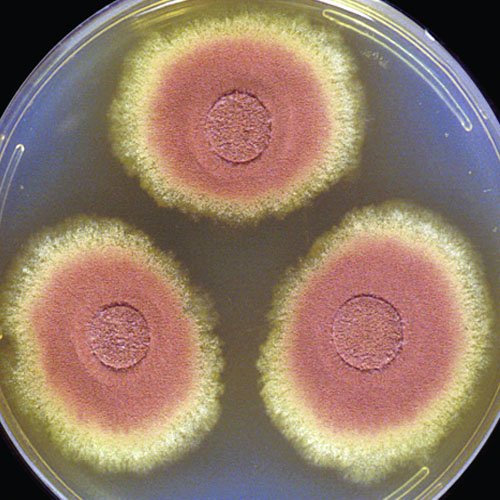
Aspergillus terreus

Total Products
Categories
Years Experience
Customer Support

Growtech Agri Science Private Limited is a leading supplier based in Indore, Madhya Pradesh.
Founder & CEO
"Our commitment to quality and customer satisfaction drives everything we do. We believe in building lasting relationships with our clients."
Scan to save contact
Growtech Agri Science Private Limited
Indore, Madhya Pradesh - 453331